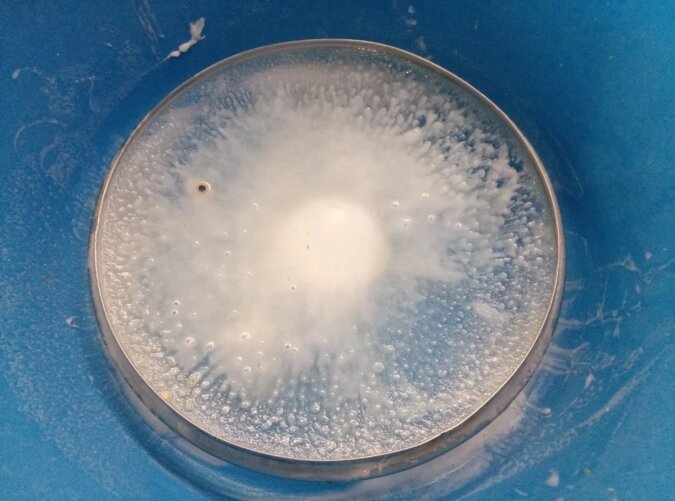

Dzisiaj podzielę się małą sztuczką, która pomoże łatwo umyć brudne pokrywki z garnków, patelni i innych naczyń. Jeśli garnek lub patelnię możemy spokojnie umyć od wszystkich stron i dostać się wszystkich zakątków, w których ukryty jest brud, to sprawy są znacznie bardziej skomplikowane w przypadku szklanej pokrywy. Tłuszcz i brud gromadzą się w najbardziej niedostępnych miejscach.
Teraz powiem i pokażę bardzo prosty sposób mycia pokrywek w domu. Zajmie to bardzo mało czasu, a niezbędne środki każdy ma swoim w dom.
Oto czego potrzebujemy:
- Brudna pokrywa – dowolna liczba sztuk
- Soda
- Nadtlenek wodoru



Na powyższym zdjęciu jest nasza bohaterka – brudna pokrywka do patelni. Ma zdejmowany uchwyt – nie wiem, czy robią teraz inne, ale jako przykład pokażę na tej.
Na początek wytrzyjmy pokrywkę do sucha, a następnie obróćmy ją uchwytem do dołu. Jeśli uchwyt można odkręcić – robimy to.
Wlewamy nadtlenek wodoru na pokrywkę. Powinien być równomiernie rozprowadzony po pokrywce. Pozostawiamy na 10 minut.

Po 10 minutach wsypujemy sodę oczyszczoną i rozprowadzamy ją na całej powierzchni pokrywki za pomocą pędzla lub gąbki. Znów odstawiamy na 5-10 minut. Sodę zmywamy dużą ilością wody za pomocą zwykłego środka do mycia naczyń.
W ciasne miejsca pokrywy można dotrzeć za pomocą cienkiego noża owiniętego małym kawałkiem tkaniny. Cały tłuszcz i brud są już mokre i natychmiast wchłaniają się w tkaninę. Możesz użyć sztywnej szczotki (tak jak ja).
To wszystko, pokrywka znów lśni i cieszy nas nieskazitelną czystością.


Główne zdjęcie: google.com

























